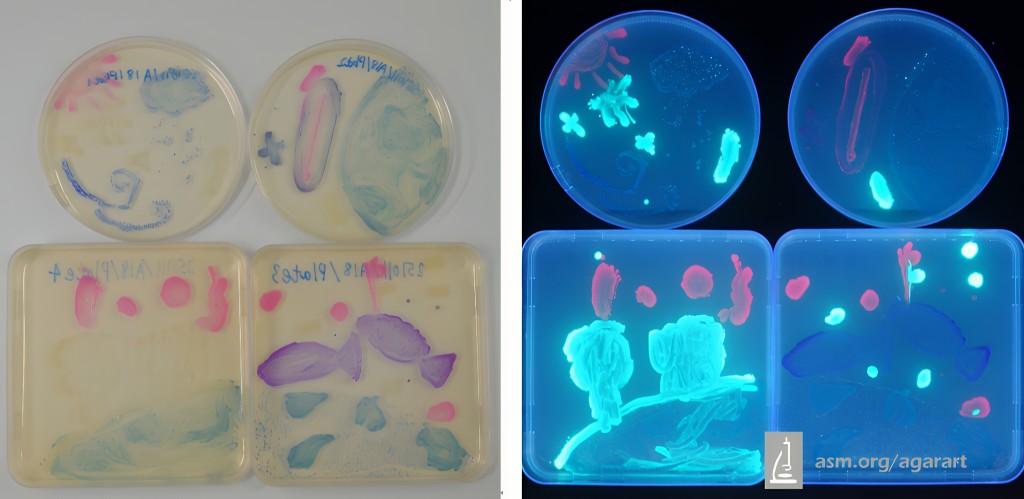
「ASM瓊脂藝術比賽2025」總決賽第五名（圖片來源：聖公會油塘基顯小學）

小小微生物驅動大世界 聖公會油塘基顯小學同學用大腸桿菌進行繪畫創作|創意貼堂區
發佈時間:16:50 2026-04-03 HKT
創意貼堂區|「國際瓊脂藝術大賽」是一項結合微生物學與藝術創意的國際 賽事,參加者需於瓊脂培養皿上利用微生物進行繪畫創作。聖公會油塘基顯小學視藝科與常識科安排兩隊五年級學生參與本港選 拔賽,應用大腸桿菌進行創作。
油塘基顯小學同學用大腸桿菌進行繪畫創作
「國際瓊脂藝術大賽」本港選拔賽共有400多名參賽者、120多隊參與,來自聖公會油塘基顯小學的兩隊隊伍分別獲得季軍和優異獎。兩隊其後代表香港參加美國「ASM瓊脂藝術比賽2025」總決賽,分別取得12歲及以下組別亞軍及第五名。學校表示,安排學生參賽旨在讓學生將科學知識與藝術創意結合,深化跨學科學習經驗,體現學校重視實踐與全人發展的教育方向。

「ASM瓊脂藝術比賽2025」總決賽亞軍

設計概念、構思及內容:
我們的設計分為衣、食、住、行四方面。
微生物與人類生活息息相關。在「衣」方面:它能處理天然纖維,製造環保的生物材料。在「食」方面:它在發酵食品中扮演重要角色,也能提高食物的風味和營養價值。而益生菌有助於消化食物,維持腸道健康。在「住」方面:微生物可以參與生物水泥的製造。而微生物對室內空氣質量、土壤健康等方面都有影響,甚至能分解有害物質,改善居住環境。在「行」方面:微生物可用於生產生物燃料,如乙醇和生物柴油。

「ASM瓊脂藝術比賽2025」總決賽第五名
設計概念、構思及內容:
我們的設計概念源於微生物與整個世界的生態息息相關,包括陸地生態、海洋生態、全球氣候變化,整個地球的生態均離不開微生物。土壤中的微生物(如細菌和真菌)參與有機物分解,促進營養循環,改善土壤結構和肥力,影響樹木的生長。海洋生態方面,微生物(如浮游植物和細菌)是海洋食物鏈的基礎,為更高層次的生物提供能量和養分。而水中微生物(如藻類和細菌)能分解有機污染物,維持水質和生態平衡。在全球氣候變化方面,微生物在碳循環中扮演關鍵角色,通過光合作用和分解作用,影響二氧化碳的固定和釋放,對全球氣候變化有重要影響。

聖公會油塘基顯小學
地址:油塘油塘道23號
查詢: 2757 0322 / [email protected]
網址: www.skhykh.edu.hk
一起分享好作品!即刻投稿
有好的創作一定要公諸同好,歡迎學校、學生投稿(所有中文作文、平面及立體視藝作品或STEAM作品皆可,題材不限,但請尊重原創,嚴禁抄襲),傳送至[email protected]。
相關文章︳以花燈在佳節傳遞溫情 樂華天主教小學學生中秋有藝 心事成畫︳創意貼堂區
相關文章︳循道學校學生畫出心中的一扇窗 展現對世界的獨特理解與情感︳創意貼堂區
相關文章︳大角嘴天主教小學青花紋樣創意再生 傳統紋飾與童趣想像交織出瓷藝新境︳創意貼堂區
相關文章︳中國團扇融合繪畫與書法 愛秩序灣官立小學視覺藝術課製作 傳承與創新美好交融︳創意貼堂區

















